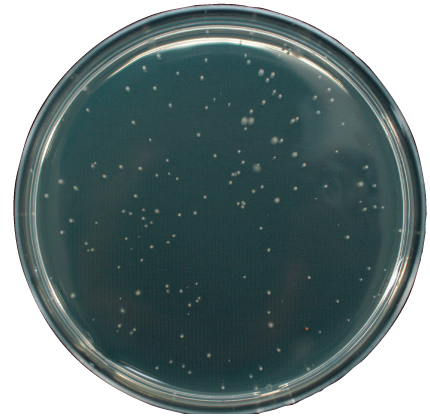
きんぎょ　さん専用出品 きんぎょのえさ5つの力 色あげ 80g | 水中生物用品・水槽用品 通販

マイストア
変更
お店で受け取る
(送料無料)
配送する
納期目安:
2025.12.20 5:29頃のお届け予定です。
決済方法が、クレジット、代金引換の場合に限ります。その他の決済方法の場合はこちらをご確認ください。
※土・日・祝日の注文の場合や在庫状況によって、商品のお届けにお時間をいただく場合がございます。
きんぎょ さん専用出品 きんぎょのえさ5つの力 色あげ 80g | 水中生物用品・水槽用品 通販の詳細情報
きんぎょのえさ5つの力 色あげ 80g | 水中生物用品・水槽用品 通販。① ちょきんぎょ グッズ おまけ付き - メルカリ。ちょい投げかんたんサビキセット | 釣具の卸売り | 世界の釣具マルシン漁具。旧作/紹チ】ちょきんぎょ チョロQ | ベア吉のおもちゃトーク♪シーズン。商品の説明はありません
ベストセラーランキングです
近くの売り場の商品
カスタマーレビュー
オススメ度 4.1点
現在、6121件のレビューが投稿されています。

























